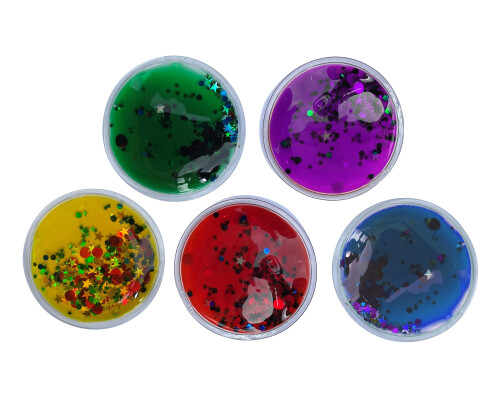
Squidgy Sparkle Circles (set Of 5)

Handheld / Fidget
This is our current list of available items and more will be added on a regular basis.

Traffic Light Ooze Tubes (set Of 3)

Pin Art Plastic Pins Set Of 3

Pin Art Metal Pins

Textured Jelly Alphabet (upper Case)

Sparkly Squidgy Letters Lower Case

Squidgy Sparkly Numbers

Sparkly Squidgy Math Symbols

Jelly Shapes (set Of 4)

Sensory Soft Bead Filled Squidgy Shapes (set Of 4)

Fidget Squidgy Textured Circles

Jelly Fish Shapes (set Of 4) New Version 2020
Squidgy Sparkle Circles (set Of 5)

Glitter Tube (pack Of 4)

Small Glitter Tube (pack Of 4)

Rainmaker
